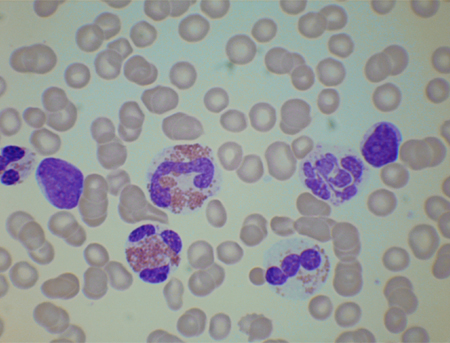

Images and videos
Images

Evaluation of eosinophilia
Blood film from a patient with chronic eosinophilic leukemia resulting from an FIP1L1-PDGFRA fusion gene. The eosinophils are partly degranulated and 1 is hypolobated
From the personal collection of Barbara J. Bain, MBBS, FRACP, FRCPath; used with permission
See this image in context in the following section/s:
Evaluation of eosinophilia
Blood film from a patient with reactive eosinophilia occurring as a response to acute lymphoblastic leukemia. There is 1 blast cell. Eosinophils are cytologically abnormal
From the personal collection of Barbara J. Bain, MBBS, FRACP, FRCPath; used with permission
See this image in context in the following section/s:
Use of this content is subject to our disclaimer